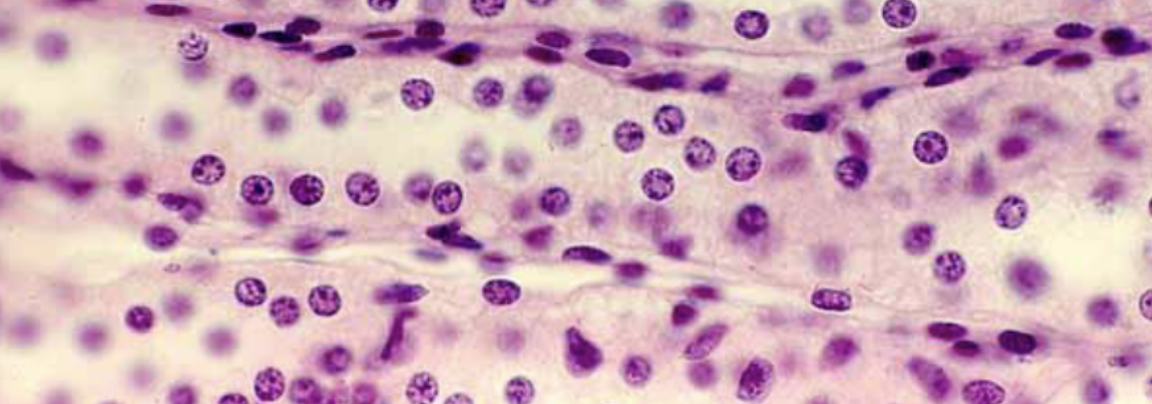
<p>What is this?</p>

1/34
Info + Photo Recognition
Name | Mastery | Learn | Test | Matching | Spaced | Call with Kai |
|---|
No analytics yet
Send a link to your students to track their progress

What is this?
Esophagus
Tissue and Muscle of Esophagus?
Stratified Squamous
Skeletal Muscle —> Smooth

What is this?
Stomach
Name 3 layers of stomach to superficial to deep, tissue, name of specialzied regions and cells produced
Longitiduail, Circular, Oblique
Simple Columnar
Parietal Cells: HCI and Insintric Factor
Cheif Cells: Pepsinogen

What is this?
Esophagus-Stomach Junction
Tissue?
Stratified Squamous —> Simple Columnar

What is this?
Small Intestine
Infoldings of small intestine? name region, glands of duedenum, lymphatic tissue, and cells that produce mucous
Villi (brush border)
DJI
Brenner’s Glands
Peyer’s Patches
Goblet Cells

What is this?
Large Intestine

Regions of Large Intestine, Tisssue, and infoldings
Many goblet cells
CADS
Crypts are simple columnar of mucosal layer
What histology looks similar to the large intestine?
Rect_m

What is this>
AN_L Canal
Type of muscle and Tissue of Canal?
Stratified Squamous
Skeletal Muscle
Difference betweeen rect_m and canal on slide?
R: cactus-like foldings
AC: rounder hills

What is this?
Larynx

Tissue of larynx
Stratified squamous epithelial tissue prior to glottis
Pseudostratified after glottis
Hyaline cartilage associated with epiglottis

What is this?
Trachea
Tissue of Trachea
Pseudostratified columnar epithelial tissue
Hyaline cartilage rings

What is this?
Bronchioles

What is this?
Alveoli
Tissue of alvoli and bronchioles? Differences on histology?
Bronchioles: Pseudostratified columnar
Alveoli: Simple Squamous
Bronchioles: Rounded Circles
Alveoli: Thin half-3/4th full circles

What is this?
Renal Corpuscle
Name of capscule, define it, what is creates, and location of Renal Corpscule
Bowman’s Capsule, that includes a single layer of specialized cells
called podocytes. The capsule surrounds a complex capillary bed called the glomerulus.
Location: Cortex

What is this?
PCT and DCT
Tissue and location of PCT/DCT
Simple cubiodal, cortex
What is this?
Loops of Henle
Location, tissue of Loops of Henle for thick and thin
Medullla—>renal columns.
Thick: simple cuboidal epithelial tissue, the thin loops by simple squamous epithelial tissue.

What is this?
Collecting Ducts
Collecting ducts location
Medulla

What is this?
Ureters
Tissue of ureters
Stratified Cuboidal until it is closer to bladder, where it is transitional

What is this?
Bladder
Tissue in Bladder?
Transitional

What is this?
Urethra (male)
Urethra tissue?
Stratified columnar